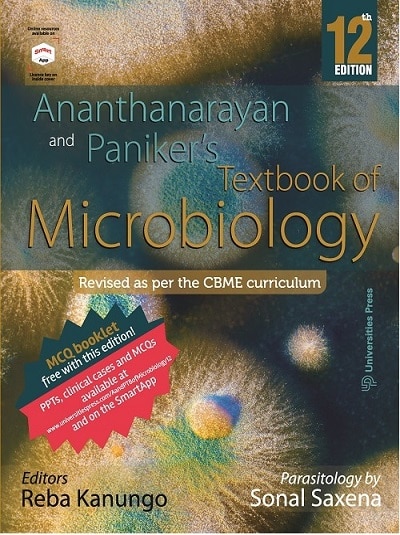
ANANTHANARAYAN AND PANIKERs TEXTBOOK OF MICROBIOLOGY | REBA KANUNGO, SONAL SAXENA | Universities Press

Books for Medical Courses
530 titles found

NEW (25%)
CLINICAL AND PRACTICAL PAEDIATRICS | HARISH K. PEMDE, VIKRAM DATTA, KAMLESH HARISH | ELSEVIER

NEW (25%)
KUMAR & CLARK'S CLINICAL MEDICINE | ADAM FEATHER, DAVID RANDALL, MONA WATERHOUSE | ELSEVIER

NEW (10%)
LEE MCGREGOR'S SYNOPSIS OF SURGICAL ANATOMY | G.A.G. DECKER, D.J. DU PLESSIS, J.A. MYBURGH | VARGHESE COMPANY

NEW (20%)
P. J. MEHTA'S PRACTICAL MEDICINE | NIHAR P. MEHTA, S. P. MEHTA, SR JOSHI | THE NATIONAL BOOK DEPOT

NEW (25%)
FIRST AID For The USMLE STEP 1 (A Student-To-Student Guide 2023) | TAO LE, VIKAS BHUSHAN, ANUP CHALISE, PANAGIOTIS KAPARALIOTIS, CONNIE QIU | McGraw Hill

NEW (20%)
ULTRASOUND TEACHING MANUAL (The Basics Of Performing And Interpreting Ultrasound Scans) | MATTHIAS HOFER | Thieme Medical Publishers

NEW (20%)
GENERAL PRACTICE | KIRTI C PATEL | THE NATIONAL BOOK DEPOT

NEW (10%)
NCISM 1st Year BAMS | शंतनू प्रकाशन (Shantanu Prakashan)
NEW (20%)
ANANTHANARAYAN AND PANIKERs TEXTBOOK OF MICROBIOLOGY | REBA KANUNGO, SONAL SAXENA | Universities Press

NEW (25%)
TEXTBOOK OF MEDICAL PHYSIOLOGY | G.K. PAL | Elsevier

NEW (30%)
DAVIDSON'S PRINCIPLES AND PRACTICE OF MEDICINE

NEW (20%)
